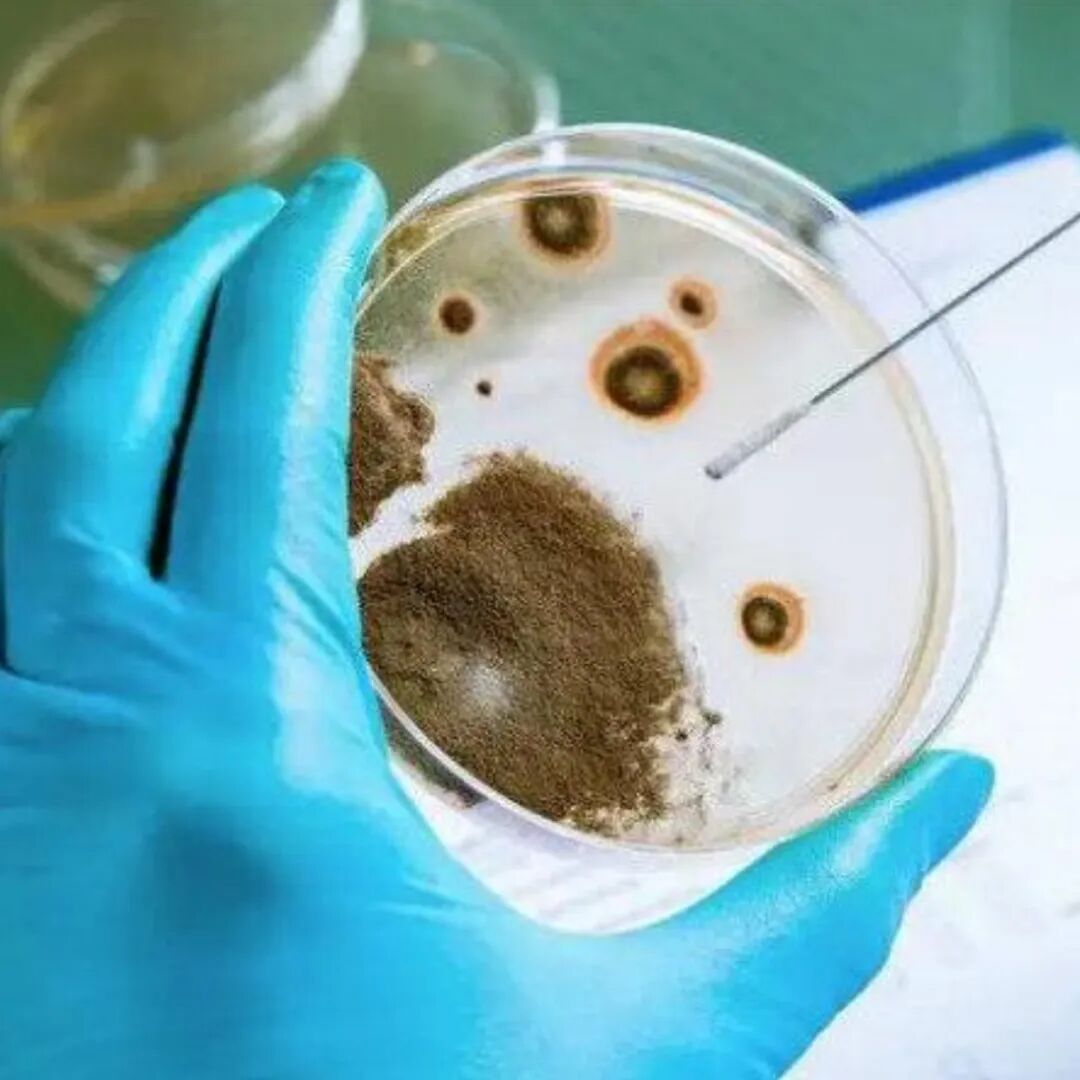

晨光映山林,显微镜藏奥秘,两天的生态科考之旅,是孩子探索自然的脚步,更是亲子并肩成长的珍贵时光,让 “生态”“地质” 从课本走进指尖、映入眼帘。
自然的演化逻辑,是否藏着我们尚未读懂的秩序?
生态系统的脆弱与坚韧,究竟由什么决定?
一片区域的生态健康,该如何被定义、被观测、被守护?
生物之间沉默的关联,又如何构成整个环境的命运共同体?
带着问题出发,以观察为尺,以科考为径,探索自然本真,读懂生态平衡。这,便是我们此行的意义。

DAY 1

野外科考
赴北京大学虎峪实习基地,完成地质考察与生态样本采集。
DAY 2

实验解码
进入科研场景,对采集的样本进行实验分析,完成科考报告。

自然是最古老的实验室。当我们以科学的视角重新审视环境,发现它是一个由严密演化逻辑支撑的庞大系统。
从初高中地理的地壳演变,到生物学中的生态系统与细胞呼吸,课本上的核心法则都需要在真实的野外环境中去观测与验证。
2天时间,我们将带领青少年深入北京大学核心地质实习基地——虎峪腹地,开展一场严谨的生态地学特训。




第一天在野外,我们通过对单斜地层、断层构造的专业测绘,以及对原状土壤、指示植被的标准化采样,解码环境演化的地质记录;
第二天在实验室,我们利用显微镜探查动植物微观结构,通过水土理化性质(pH值等)的滴定测试与活细胞呼吸作用的生化验证,探究“土壤-植被-地质”的耦合特征。
我们希望通过真实的科研工作流,让青少年掌握科学探究的基本范式,培养真正具备严谨科学素养、能够以客观数据审视生物多样性的青年观察者。

DAY 1
野外科考
地质科考:读懂地球的 “万卷书”

行程形式:亲子户外(11 周岁以上可单飞)
行程地点:北京虎峪自然风景区(北大地质实习基地)
时间参考:
08:30 中关村集合乘车出发 →
09:30 抵达虎峪 →
09:30-15:30 野外科考实践 → 15:30 集合返程
典型地质现象实地观测
✅ 单斜地层:

解读万卷书 般的层理结构,识别深浅不同岩层对应的岩石类型与古海洋沉积环境,读懂地球演化的时间刻度;
✅ 断层与特殊构造:

实地观测地壳运动形成的教科书级断层,探寻地层错断的成因;寻找标志性的石香肠构造,理解岩石挤压变形的力学原理;
✅ 河流阶地与岩浆活动遗迹:

学习河流阶地的识别方法,解析其与地质运动、气候变化的关联;识别岩浆侵入形成的岩床、岩墙,解锁岩浆活动的直接证据;
✅ 三大岩类系统认知:



现场识别岩浆岩、沉积岩、变质岩三大岩石类型,掌握各类岩石的形成特征与鉴别方法,读懂地球的岩石语言。
规范地质采样与测绘记录
✅ 标本采集:

系统采集岩浆岩、沉积岩、变质岩三大岩类标本,建立完整的岩性样本库;
✅ 精准测量与记录:

精细测量沉积岩厚度变化,绘制地层剖面示意图,还原沉积序列;精准测定地层产状(倾向、倾角),掌握岩层空间展布规律;测算断层断距,综合判定断层性质(正 / 逆 / 平移断层);分析沉积岩粒度特征,反演古水动力条件,重建古沉积环境;
✅ 专业地质绘图:

绘制河流横截面示意图,解析河道地貌与沉积特征;绘制单斜、褶皱、断层、石香肠等典型地质构造示意图,直观还原构造变形与演化过程。
采集生态系统的核心样本
✅ 生态学基础理论启蒙:
系统讲解生态学核心概念、生态系统结构与功能、生物与环境的相互关系等基础理论,建立科学的生态认知框架,为野外实践奠定扎实基础。
✅ 植物标本规范采集:

在指定区域内,采集不同树种的完整叶片、树皮特征样本,观察记录叶片形状、叶缘、叶序、树皮纹理、颜色、质地等形态特征,学习规范的标本采集、分类与初步整理方法。
✅ 土壤样本规范采集:

按科研标准完成不同区域的土壤样本采集,了解采样点环境、土层结构与土壤基本性状,严格完成样本的收集、编号与规范记录,为后续实验室检测提供标准、可靠的实验材料,掌握土壤野外采样的科学方法。
DAY 2
实验解码
生态机理实验分析

行程形式:青少年单飞(家长不可陪同)
行程地点:专业科研院所实验室
时间:09:00-16:00 全流程实验室实操
实验一:树叶的指纹密码 —— 植物形态与适应性分析

✅ 叶片采集:在公园内采集5-8种不同树木的叶片(第一天已采集)
✅ 特征观察:用放大镜观察叶片的形状、边缘、叶脉、质地等特征
✅ 分类记录:根据叶片特征进行分类,记录每种叶片的树种名称
✅ 制作标本:将叶片用胶带固定在硬纸板上,标注树种和采集日期
✅ 对比分析:比较不同树种的叶片特征,讨论这些特征如何帮助植物适应环境
实验二:树皮上的生命画廊 —— 附生群落与环境指示

✅ 树皮观察:选择不同树种,观察树皮的颜色、纹理和湿度
✅ 生物发现:寻找树皮上的苔藓、地衣、真菌、昆虫等
✅ 细致观察:用放大镜观察苔藓和地衣的结构
✅ 湿度测试:比较不同朝向树干上的生物分布
✅ 生态关系分析:讨论附生生物与树木是共生还是寄生关系
✅ 环境指示:了解地衣作为空气质量指示生物的作用
实验三:会呼吸的绿肺 —— 植物呼吸作用机理验证

植物和动物一样,每时每刻都在进行呼吸作用。呼吸作用是指活细胞在氧气的参与下,将有机物(如淀粉)分解成二氧化碳和水,并释放能量的过程。 二氧化碳能使澄清的石灰水变浑浊、氧气能助燃(支持燃烧)、呼吸作用释放热量。
✅ 实验A:呼吸作用释放二氧化碳(验证产物)
✅ 实验B:呼吸作用消耗氧气(验证反应物)
实验四:大地母亲的营养配方 —— 土壤与水环境因子检测

采集自不同地点的水样,不同地点的土样
✅ 水的酸碱度(pH)测定
✅ 水的硬度简易测试(泡沫实验)
✅ 土壤酸碱度(pH)测定
✅ 土壤质地与保水性探究
课程总结

系统复盘两日科考的核心内容,梳理生态学基础概念、生态系统结构与功能、生物与环境的相互关系等核心知识,巩固科学认知,强化科学观察能力与生态保护意识。

对标课标与专业标准的知识体系
系统掌握初高中地理、生物核心知识点,同步北大地学实习营的专业教学标准,建立地质 - 土壤 - 植被耦合系统的完整科学认知,打破课本知识与野外实践的壁垒。
全流程规范的科研实操能力
熟练掌握野外地质观测、标本规范采集、地层产状测量、地质绘图、实验室样本检测、数据记录分析等全链条科研方法,养成严谨、规范的科学操作习惯。
完整的科学思维启蒙
完成从提出科学问题、野外调查验证、实验机理分析到总结复盘的完整科研闭环,学会用科学的视角观察自然、用严谨的逻辑分析问题,建立系统的科学思维模式。
根植内心的生态保护理念
在实地观测与实验中读懂自然演化的底层逻辑,理解生态系统的脆弱与坚韧,建立科学的生态保护认知,成长为生物多样性的守护者、生态文明的践行者。

需要准备什么物品?
外衣建议选择保暖抗风款式,内搭穿轻薄吸汗衣物,夹层可根据自身体感灵活搭配。近期天气寒冷,请务必注意防寒保暖。请个人自备帽子、防寒套装,雨具可根据自身需求及天气情况自行准备。
午饭怎么安排?
第一天午饭请自行准备路餐一份,严禁携带自热类食品。建议自备补给:巧克力、葡萄干、牛肉干、能量胶、盐丸。饮用水建议携带 1–1.5L,可根据个人需求酌情增减。
第二天科学院所食堂就餐,食堂自选。
孩子需要自备常用药吗?
建议根据孩子身体情况自行准备常用药品(如过敏药、肠胃药等),并提前告知用法用量。带队老师也会携带急救包和基础应急药品,但特殊需求请务必自备,确保安全。
活动一共几天?每天形式一样吗?
共 2 天。
第一天:亲子活动,11 周岁以上可以单飞。
第二天:孩子独立室内实验,家长不可陪同。
两天地点一样吗?
两天行程地点不一样。
第一天参考到达时间为 8:30,
第二天为 8:50,具体时间以后续通知为准。